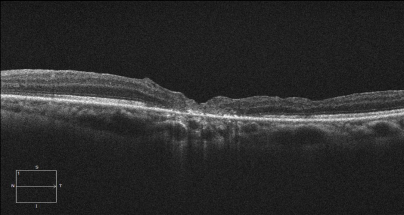

黄斑裂孔是指黄斑部视网膜神经上皮层的全层组织缺损,好发于50岁以上的老年人及高度近视患者。患者主要表现为视力减退及视物变形。黄斑裂孔目前暂时没有有效的治疗药物,视力下降明显或视物变形严重者可以行治疗性玻璃体切割术,目的在于促使黄斑裂孔闭合及裂孔周围视网膜浅脱离复位。特发性黄斑裂孔玻璃体切割手术时剥除内界膜已经成为共识,但对于裂孔较大或者高度近视黄斑裂孔,单纯剥除内界膜可能并不够,术后裂孔不容易愈合,容易复发视网膜脱离,近年来研究显示将内界膜或者羊膜移植到黄斑裂孔表面可以促进裂孔的闭合,可以用来治疗较大的黄斑裂孔。
在黄斑裂孔处移植内界膜或者羊膜,可以使裂孔处形成相对封闭的环境,视网膜下液逐渐吸收后视网膜即可复位,裂孔中的内界膜或者羊膜不会作为异物阻碍裂孔的闭合过程,相反会为胶质细胞提供支架,促进神经胶质细胞增生,从而拉动光感受器细胞向裂孔中心移位,促进裂孔闭合。
我科近几年利用内界膜或者生物羊膜填塞治疗黄斑裂孔,重塑了黄斑结构,大大提高了黄斑裂孔的治愈率,使患者术后视力显著提高,改善了患者的生活质量,开创了黄斑裂孔治疗的新思路,为黄斑裂孔患者带来了福音。
患者陈某,女,48岁,因左眼视物变形半年入院,入院时左眼视力为0.02,诊断为左眼黄斑裂孔,在我科行左眼玻璃体切割联合内界膜填塞术后,患者自觉视物变形症状明显好转,术后一月门诊复查左眼视力提高到0.12,黄斑裂孔已修复。门诊复查左眼黄斑区OCT如下图所示:
患者于某,女,52岁,因左眼视力下降一年入院,入院时左眼视力为数值/30cm,诊断为左眼黄斑裂孔,在我科行左眼玻璃体切割联合生物羊膜填塞黄斑裂孔,术后一周复查OCT可见黄斑裂孔已基本修复,如下图所示:

服务热线
服务热线
版权所有: 重庆医科大学附属第二医院 | Copyright @ 2016-2026 CQSAHCQMU.CN All Right Reserved. 渝ICP备15009793号-10 渝公网安备 50010302000990号
技术支持:瑞秀科技
